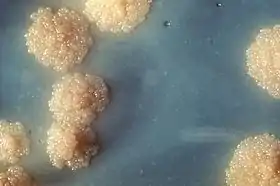

طب تطوري
الطب التطوري أو الطب الدارويني هو تطبيق نظرية التطور الحديث لفهم ماهية الصحة والمرض. حيث يوفر منهجًا علميًا مكملاً لمنهج التفسيرات الآلية المعاصر الذي يسيطر على العلوم الطبية وخاصة التعليم الطبي الحديث. لقد اقترح الباحثون في مجال الطب التطوري أن علم الأحياء التطوري يجب ألّا يكون مجرد موضوع اختياري بكلية الطب، ولكن بدلًا من ذلك يجب تدريسه كأحد العلوم الطبية الأساسية.[1]
وهذه التكيفات تهتم بما يلي:
- تطور العوامل المسببة للمرض من حيث حدتها والمقاومة تجاه المضادات الحيوية وتدمير الجهاز المناعي للفرد.
- العمليات والمعوقات والمقايضات المتعلقة بالتطور البشري.
- الاستجابات المنبثقة التي تمكن الأفراد من حماية أنفسهم ومعالجتها وتعافيها من حالات العدوى والإصابات مثل المناعة والحمى وسلوك المرض، والعمليات التي تنظم انتشارها من أجل زيادة اللياقة لأقصى درجة.
- كيف أن التكيف الماضي الذي قام به البشر الأوائل تجاه بيئة الأسلاف يؤثر الآن على البشر المعاصرين باختلاف النظام الغذائي ومتوسط العمر المتوقع ودرجة التمرينات الرياضية والنظافة فيما بينهم.
ويتضمن الباحثون الكبار في مجال الطب التطوري: راندولف إم نيسي (Randolph M. Nesse) وجورج سي ويليامز (George C. Williams) وبول دابليو إيوالد (Paul W. Ewald) وجيمس ماكينا (James McKenna) وبول دابليو تيرك (Paul W. Turke) وراينر إتش ستراوب (Rainer H. Straub).
معلومات تاريخية

لم يناقش تشارلز داروين تطبيقات عمله من أجل الطب رغم أن علماء الأحياء سرعان ما أعطوا الكثير من التقدير من أجل نظرية جرثومية المرض نظرًا لتطبيقاتها من أجل فهم تطور العوامل المسببة للمرض وحاجة أي كائن للدفاع عن نفسه ضدها.
ولكن الطب بدوره تجاهل نظرية التطور ووجه تركيزه بدلًا من ذلك (كما تم في العلوم البحتة) على الأسباب الآلية المتقاربة.
لقد سار الطب على خطى الفيزياء الميكانيكية المشتقة عن جاليليو (Galileo) ونيوتن (Newton) وديكارت (Descartes)…. ونتيجة لتبني هذا النموذج، فإن الطب يعتبر ميكانيكيًا وماديًا واختزاليًا وخطيًا سببيًا، وكذلك حتميًا (قادرًا على تقديم تنبؤات دقيقة) في مفاهيمه. حيث يبحث عن تفسيرات للأمراض أو أعراضها وعلاماتها والسبب في التغيرات الفردية المادية - ونعني بهذا التشريحية أو الهيكلية (مثل الجينات ومنتجاتها) - داخل الجسم التي تحدث مباشرة (بشكل خطي) على سبيل المثال بواسطة العوامل المعدية أو السامة أو المسببة للجروح.[2] ص 510
لقد كان جورج سي ويليامز أول من طبق نظرية التطور على الصحة في سياق الشيخوخة.[3] وكذلك في فترة الخمسينيات، اقترب جون باولبي (John Bowlby) من مشكلة مقاطعة عملية تطور الأطفال من منظور تطوري عند التعامل مع هذا الأمر.
وكان أحد التطورات النظرية المهمة تفرقة نيكولاس تنبرغن (Nikolaas Tinbergen) التي تمت في الأصل في علم الإيثولوجيا بين آليات التطور والتقارب.[4]
لقد لخص راندولف نيسي (Randolph Nesse) ارتباطها بالطب كما يلي:
جميع الآثار الحيوية تحتاج لنوعين من التفسير؛ وكلاهما يعتمد على التقارب والتطور. يصف التفسير التقاربي لمرض ما هو خطأ في الآلية الجسدية للأفراد المصابين بهذا المرض. ولكن التفسير التطوري مختلف تمامًا. فبدلًا من تفسير أسباب اختلاف الأشخاص؛ فإنه يفسر لماذا نحن جميعًا متساوون في الطرق التي تتركنا عرضة للمرض. لماذا كلنا لدينا ضرس العقل والزائدة الدودية والخلايا التي يمكن أن تنقسم وتخرج عن نطاق السيطرة؟[5]
لقد كان بحث بول إيوالد (Paul Ewald) عام 1980 بعنوان "الأحياء التطورية ومعالجة علامات وأعراض الأمراض المعدية"[6] وبحث ويليامز ونيسي عام 1991 بعنوان "فجر الطب الدارويني"[7] بمثابة تطورات رئيسية. فالبحث الأخير "لاقى استقبالاً حافلاً" [8]الصفحة x وأدى إلى ظهور كتاب لماذا نمرض (نشر تحت اسم التطور والعلاج بالمملكة المتحدة). وفي عام 2008، بدأت صحيفة إلكترونية عبر الإنترنت في إصدار: نشرة التطور والطب.
العوامل المسببة للمرض
لعب التطور التكيفي للبكتريا والفيروسات والميكروبات الأخرى والطفيليات دورًا مركزيًا في الطب إذ أن هذه العملية ضرورية لفهم قضايا مثل مقاومة المضادات الحيوية[9] وحدة العوامل المسببة للأمراض[10] وتدمير العوامل المسببة لأمراض للجهاز المناعي.[11]
مقاومة المضادات الحيوية
تظهر الكائنات الدقيقة مقاومة من خلال الانتقاء الطبيعي المعتمد على الطفرة العشوائية. بمجرد أن يظهر الجين المانح للمقاومة ليبطل مفعول مضاد حيوي؛ فلا يكون بمقدور تلك البكتريا أن تنمو فحسب، بل يمكنها أيضًا أن تنشر هذا الجين إلى الأنواع الأخرى من البكتريا من خلال نقل المورثات الأفقي للمعلومات الجينية بواسطة تبادل البلازميدات.
لمزيد من التفاصيل حول هذا الموضوع، انظر مقاومة المضادات الحيوية
الفوعة (القدرة على نقل العدوى)
إن تأثير الكائنات على مضيفها قد يختلف بين أن يكون تعايشيا تطفليا وكلاهما يعتبر مفيدًا بالنسبة للعوامل المسببة للأمراض التي تقلل اللياقة. كذلك، فإن العديد من العوامل المسببة للأمراض تنتج عوامل الفوعة والتي تتسبب في حدوث المرض بصورة مباشرة أو تستغل مضيفها ليسمح لها بالنمو والانتشار. ونظرًا لأن لياقة العوامل المسببة للأمراض تتحدد من خلال نجاحها في نقل السلالة إلى مضيفات أخرى، فقد كان هناك اعتقاد في وقت ما أن القدرة على نقل العدوى قد قل مستواها وتطورت إلى التطفل. ورغم ذلك، فإن نظرية إيوالد تشكك في هذا الرأي في الوقت الحاضر.
لمزيد من التفاصيل حول هذا الموضوع، انظر الفوعة وعامل الفوعة والمعدل الأمثل للفوعة
تجنب المناعة
إن نجاح أي عامل مسبب للمرض يعتمد على قدرته على تجنب جهاز المناعة لدى المضيف. وبناءً على ذلك، فإن العوامل المسببة للمرض تنتج طرقًا تمكنها من نقل العدوى إلى مضيف ما ثم تجنب اكتشافها وتدميرها من قِبل جهازه المناعي. وهذه الطرق تتضمن الاختباء داخل خلايا المضيف وداخل غلاف واقٍ (كما يحدث مع المتفطرة السلية) والتي تفرز مركبات تضلل استجابة مناعة المضيف وتعوق حركة الأجسام المضادة لديه، مما يعمل بسرعة على تغيير علامات السطح أو تخفيها داخل جزيئات المضيف.
لمزيد من التفاصيل حول هذا الموضوع، انظر استغلال العوامل المسببة للمرض لجهاز المناعة، وتجنب الجهاز المناعي الطبيعي
وسائل التكيف البشرية
يعمل التكيف في إطار من المعوقات ويقوم بعمل مفاضلات وتبادلات ويظهر في سياق أشكال مختلفة من التنافس.[12]
المعوقات
لا يمكن أن تحدث وسائل التكيف إلا إذا كانت قابلة للتطور. ومن ثم فبعض وسائل التكيف التي ربما تمنع ضعف الصحة لا تكون ممكنة.
- لا يمكن منع الحمض النووي الريبوزي منقوص الأكسجين (DNA) كليةً من القيام بعملية تضاعف ذاتي الطفرة وهذا يعني أن السرطان والذي يحدث نتيجة للتضاعف الذاتي لايمكن أبدًا التخلص منه بواسطة الانتقاء الطبيعي.
- لا يستطيع البشر القيام بعملية التخليق الحيوي لـ فيتامين سي وبذلك يتعرضون لمخاطر الإسقربوط، وهو مرض النقص الشديد في فيتامين سي إذا كانت الجرعات الغذائية من فيتامين سي غير كافية.
- العصيبات الشبكية ومخرجاتها المحورية تطورت لتصبح داخل طبقة الخلايا الصبغية الشبكية. وهذا يصنع معوقًا يحول دون تطور الجهاز البصري حتى أن العصب البصري يجبر على الخروج من الشبكية من خلال نقطة تسمى القرص البصري. وهذا بدوره يؤدي إلى نشوء بقعة عمياء. والأكثر أهمية أنه يجعل الرؤية معرضة لحدوث زيادة الضغط داخل العين (المياه الزرقاء) حيث يؤدي هذا إلى التحجيم ويدمر العصب البصري عند هذه النقطة مما يؤدي إلى ضعف الرؤية.
وقد تحدث بعض المعوقات الأخرى مثل المنتج الثنائي للابتكارات التكيفية.
المقايضات والتضاربات
من معوقات الانتقاء أن وسائل التكيف المختلفة قد تتضارب، وهو ما يتطلب إجراء مفاضلة بينها لضمان إجراء أفضل مفاضلة بين التكلفة والفائدة المتحققة.
- كفاءة الركض لدى السيدات وحجم قناة الولادة[13]
- التدمغ وحجم القناة الهضمية [14]
- تصبغ الجلد الحماية من الأشعة فوق البنفسجية (UV) وتخليق الجلد لـ فيتامين د
- الخطاب واستخدامه لـ الحنجرة_الهابطة وزيادة خطر الاختناق[15]
آثار التنافس
توجد أشكال مختلفة من التنافس وربما تشكل عمليات التغير الجيني.
- انتقاء الزوج وسرعة التأثر بالمرض [16]
- التنافر الجينومي بين الأم والجنين مما يؤدي إلى مقدمات الارتجاع[17][18]
- مركب التوافق النسيجي الكبير انتقاء الزوج[19][20]
- التنافس الجيني الأبوي الأمي والذي من خلال تغييرالبصمة الوراثية يمكن أن يتعرض لخطر التوحد وانفصام الشخصية[21]
ظهور آليات الدفاع
للتطور آليات دفاعية منتقاة تحمي من الإصابات وحالات العدوى.[22] ومن بينها ما يلي
- القلق
- الحمى
- فرط التألم
- نقص حديد الدم
- الحكة
- الخمول
- الاكتئاب
- غثيان الصباح
- الغثيان
- الألم
- النعاس
- السلوك المرضي (الخمول، والاكتئاب وفقدان الشهية، والنعاس، وقلة التزين والإخفاق في التركيز)
- الإخراجات: العطس والقيء والسعال والإسهال
- التدابير العلاجية
قد تكون آليات الدفاع الناشئة مرتفعة التكاليف بسبب ازدياد استخدام الطاقة (تزيد الحمى من معدل الاستقلاب الأساسي (BMR) بنسبة ما بين 10 إلى 15% مقابل ارتفاع درجة حرارة الجسم لكل درجة) ونتيجة لمخاطر إتلاف الجسد (القيء يمكن أن يسبب خطرًا على التنفس). ومن ثم فهناك ميزة اللياقة من خلال نشر آليات الدفاع انتقائيًا فقط عندما تزيد المنافع المحتملة على هذه التكاليف. يتم التحكم في انتشارها من خلال عدة مستويات، بما يتضمن مسارات الجزيئات الحيوية من خلال استخدام عناصر مثل السيتوكين المحفز للالتهاب ومن خلال معدل مرتفع من عمليات التحكم العصبي من أعلى لأسفل التي تحدث في قشرة المخ مثل القشرة المعزولة. ويوفر التحكم العصبي ميزات في هذا الانتشار يمكن أن تعتمد على المفاضلات بين التكاليف والمنافع التي تراعي الظروف الصحية المرتبطة. وتعمل هذه الإجراءات الناتجة باعتبارها نظام للإدارة الصحية.[23]
"أمراض المدنية"
تطور البشر تدريجيًا ليعيشون على الصيد وجمع الثمار في مجموعات قبلية صغيرة؛ إنها حياة وبيئة مختلفة تمامًا عن التي يواجهها البشر المعاصرون.[24][25] وهذا التغيير جعل الإنسان المعاصر معرضًا لعدد من المشكلات الصحية والتي اصطلح على تسميتها "أمراض المدنية" و"أمراض الرفاهية".
النظام الغذائي
على العكس من النظام الغذائي الخاص بـ الصيادون وجامعو الثمار الأوائل، فإن النظام الغذائي العصري يحتوي على كميات مرتفعة من الدهون والأملاح والسكر المكرر. وهذه المأكولات تتسبب في حدوث مشكلات صحية.[26][27][28]
- المخاطر الصحية للدهون المتحولة
- تسوس الأسنان
- الأغذية مرتفعة المؤشر الجلايسيمي
- النظام الغذائي الحديث يعتمد على "الحكمة العامة" تجاه الأنظمة الغذائية في العصر الحجري
متوسط العمر المتوقع
التمرينات الرياضية
يمارس البشر المعاصرون قدرًا ضئيلاً من التمرينات الرياضية مقارنةً بنمط الحياة النشط بدنيًا لدى أسلافهم من الصائدين وجامعي الثمار.[29][30][31][32][33] تم اقتراح أنه بناءً على أن فترات الخمول الطويلة يمكن أن تقع فقط في الفترات الأولى التي تلى مرض الإنسان أو إصابته، فإنها تقدم إشارة إلى الجسم لينخرط في أنشطة تمثيل غذائي تحافظ على الحياة واستجابات متعلقة بالضغط مثل الالتهاب تعتبر الآن سببًا للعديد من الأمراض المزمنة.[34]
النظافة
البشر المعاصرون - بسبب العلاج الطبي وتكرار غسيل الملابس والجسم والأدوات الصحية المتقدمة - يكونون غالبًا غير مصابين بـ الطفيليات، وخاصة المعوية. وهذا يحدث مشكلات في التطور الصحيح للجهاز المناعي.
- أمراض المناعة الذاتية
- حالات الحساسية
- فرضيات العادات الصحية
- العلاج من الديدان
تفسيرات محددة
هذه قائمة جزئية: جميع الروابط هنا تنتقل إلى قسم يصف أو يناقش أصلها التطوري.
ما يتعلق بمراحل الحياة
- النسيج الدهني لدى الرضع من البشر[35]
- التهاب المفاصل وأمراض التهابية مزمنة أخرى[36][37][38]
- تقدم العمر[3][12]
- مرض الزهايمر[39]
- الطفولة[40]
- بدء الإحاضة[41]
- انقطاع الطمث[42]
- الحيض[43][44][45]
- غثيان الصباح[46][47]
أمراض أخرى
- التصلب العصيدي[48]
- التهاب المفاصل وأمراض التهابية مزمنة أخرى[36][37][38]
- السعال[8]
- التليف الكيسي[49]
- إطباق أسناني[50]
- داء السكري من النمط الثاني[51][52]
- الإسهال[53]
- فرط ضغط الدم الأساسي[54]
- الحمى[55][56]
- النقرس[57]
- داء ترسب الأصبغة الدموية[58][59]
- نقص الحديد (الفوائد التناقضية)[60]
- السمنة[61][62]
- فينايلكيتونوريا[63]
- الأدوية الوهمية[23]
- هشاشة العظام[64]
- اضطرابات تعدد أشكال خلايا الدم الحمراء[65]
- فقر الدم المنجلي[66][67]
- السلوك المرضي[68]
- سرطان الجهاز التناسلي لدى النساء[69]
طب النفس التطوري / طب النفس التطوري السريري
كما هو مشار إليه في الجدول أدناه، فإن الافتراضيات التكيفية المتعلقة بعلم أسباب الأمراض الخاص بالاضطراب الفسيولوجي غالبًا ما تعتمد على تناظرات ذات وجهات نظر تطورية حول الطب والاختلال الوظيفي الفسيولوجي (انظر تحديدًا راندي نيسي وجورج سي. ويليامز بعنوان لماذا نمرض).[70] ويزعم أطباء طب النفس التطوري وعلماء النفس أن بعض الاضطرابات العقلية غالبًا ما تكون لها أسباب عديدة.[71]
| الأسباب الممكنة لـ"حالات الشذوذ النفسي" من منظور تكيفي اعتمد الملخص على المعلومات الموجودة في Buss (عام 2011),[72] Gaulin & McBurney (عام 2004),[73] Workman & Reader (عام 2004)[74] | ||
|---|---|---|
| السبب المحتمل | خلل وظيفي فيسولوجي | خلل وظيفي سيكولوجي |
| التكيف الوظيفي (الدفاع التكيفي) | الحمى / التقيؤ (استجابة وظيفية تجاه العدوى أو ابتلاع مادة مسممة) | اكتئاب غير حاد أو قلق (استجابات وظيفية للخسارة غير الحادة أو الضغط) |
| منتج ثانوي لعملية (عمليات) تكيف | الغازات المعوية (منتج ثانوي لابتلاع الألياف) | حالات الولع الجنسي (?) (منتج ثانوي للتكيف مع الإثارة الجنسية الطبيعية التي "انطبعت" على أشياء أو مواقف غير طبيعية) |
| التكيفات ذات الآثار المتعددة | جين مقاومة الملاريا، في شكل متماثل الزيجوت، يتسبب في حدوث فقر الدم المنجلي | عملية (عمليات) التكيف للمستويات العليا من الإبداع يمكن أن تكون أيضًا عبارة عن ميل إلى انفصام الشخصية أو تعكر المزاج ثنائي القطب (عمليات التكيفات ذات الآثار الإيجابية والسلبية بالطبع تعتمد على مسارت تطور تبادلية) |
| قصور التكيف | الحساسيات (الاستجابات الزائدة للمناعة الذاتية) | التوحد (القصور المحتمل لوحدة نظرية العقل) |
| متكرر-مستقل كل وحدة | الجنسان / أنواع مختلفة من الدم والمناعة | السمات الشخصية واضطرابات الشخصية (يمكن أن توفر إستراتيجيات سلوكية تعتمد على تكرار الإستراتيجية في القطاع السكاني) |
| عدم التوافق بين بيئة الأسلاف والبيئة المعاصرة | سكري النمط الثاني للنظام الغذائي الحديث | المزيد من التفاعل المتكرر مع الغرباء (مقارنة بالأسرة والأصدقاء المقربين) ربما يسبب الميل بدرجة أكبر للإصابة بالاكتئاب والقلق |
| نهاية المنحنى (الشكل الجرسي) الطبيعي ( | ارتفاع شديد القصر أو الطول | نهايات توزيع السمات الشخصية (على سبيل المثال شديد الانطواء أو الانبساط) |
انظر العديد من مجالات الموضوعات والمراجع المصاحبة أدناه.
انظر أيضًا
المراجع
- Nesse, RM; et al. (2009). "Making evolutionary biology a basic science for medicine". Proceedings of the National Academy of Sciences of the United States of America. PNAS. Suppl 1 (suppl_1): 1800–7. doi:10.1073/pnas.0906224106. PMC 2868284. PMID 19918069. مؤرشف من الأصل في 6 ديسمبر 2018. الوسيط
|CitationClass=تم تجاهله (مساعدة) - Weiner H (1 July 1998). "Notes on an evolutionary medicine". Psychosom Med. 60 (4): 510–20. PMID 9710299. مؤرشف من الأصل في 28 مارس 2020. الوسيط
|CitationClass=تم تجاهله (مساعدة) - Williams GC (1957). "Pleiotropy, Natural Selection, and the Evolution of Senescence" (PDF). Evolution. Society for the Study of Evolution. 11 (4): 398–411. doi:10.2307/2406060. JSTOR 2406060. مؤرشف من الأصل (PDF) في 19 سبتمبر 2006. الوسيط
|CitationClass=تم تجاهله (مساعدة) abstract - Tinbergen N (1963). "On Aims and Methods in Ethology" (PDF). Zeitschrift für Tierpsychologie. 20 (4): 410–433. doi:10.1111/j.1439-0310.1963.tb01161.x. مؤرشف من الأصل (PDF) في 28 مارس 2020. الوسيط
|CitationClass=تم تجاهله (مساعدة) - Nesse RM (2008). "Evolution: medicine's most basic science". Lancet. 372 (Suppl 1): S21–7. doi:10.1016/S0140-6736(08)61877-2. الوسيط
|CitationClass=تم تجاهله (مساعدة) - Ewald PW (1980). "Evolutionary biology and the treatment of signs and symptoms of infectious disease". J. Theor. Biol. 86 (1): 169–76. doi:10.1016/0022-5193(80)90073-9. PMID 7464170. مؤرشف من الأصل في 19 يونيو 2018. الوسيط
|CitationClass=تم تجاهله (مساعدة) - Williams GC, Nesse RM (1991). "The dawn of Darwinian medicine". Q Rev Biol. 66 (1): 1–22. doi:10.1086/417048. PMID 2052670. الوسيط
|CitationClass=تم تجاهله (مساعدة) - Williams, George; Nesse, Randolph M. (1996). Why we get sick: the new science of Darwinian medicine. New York: Vintage Books. ISBN 0-679-74674-9. الوسيط
|CitationClass=تم تجاهله (مساعدة)صيانة CS1: أسماء متعددة: قائمة المؤلفون (link) - Stearns SC, Ebert D (2001). "Evolution in health and disease: work in progress". Q Rev Biol. 76 (4): 417–32. doi:10.1086/420539. PMID 11783396. الوسيط
|CitationClass=تم تجاهله (مساعدة) - Wickham ME, Brown NF, Boyle EC, Coombes BK, Finlay BB (2007). "Virulence is positively selected by transmission success between mammalian hosts". Curr. Biol. 17 (9): 783–8. doi:10.1016/j.cub.2007.03.067. PMID 17442572. الوسيط
|CitationClass=تم تجاهله (مساعدة)صيانة CS1: أسماء متعددة: قائمة المؤلفون (link) - Finlay BB, McFadden G (2006). "Anti-immunology: evasion of the host immune system by bacterial and viral pathogens". Cell. 124 (4): 767–82. doi:10.1016/j.cell.2006.01.034. PMID 16497587. الوسيط
|CitationClass=تم تجاهله (مساعدة) - Stearns SC (2005). "Issues in evolutionary medicine". Am. J. Hum. Biol. 17 (2): 131–40. doi:10.1002/ajhb.20105. PMID 15736177. الوسيط
|CitationClass=تم تجاهله (مساعدة) - Sagan, Dorion; Skoyles, John R. (2002). Up from dragons: the evolution of human intelligence. New York: McGraw-Hill. صفحات 240–1. ISBN 0-07-137825-1. الوسيط
|CitationClass=تم تجاهله (مساعدة)صيانة CS1: أسماء متعددة: قائمة المؤلفون (link) - Aiello LC, Wheeler P (1995). "The Expensive-Tissue Hypothesis: The Brain and the Digestive System in Human and Primate Evolution". Current Anthropology. 36 (2): 199–221. doi:10.1086/204350. الوسيط
|CitationClass=تم تجاهله (مساعدة) - Lieberman P (2007). "The Evolution of Human Speech: Its Anatomical and Neural Bases" (PDF). Current Anthropology. 48 (1): 39–66. doi:10.1086/509092. مؤرشف من الأصل (PDF) في 28 نوفمبر 2019. الوسيط
|CitationClass=تم تجاهله (مساعدة) - Howard RS, Lively CM (2004). "Good vs complementary genes for parasite resistance and the evolution of mate choice". BMC Evol Biol. 4 (1): 48. doi:10.1186/1471-2148-4-48. PMC 543473. PMID 15555062. الوسيط
|CitationClass=تم تجاهله (مساعدة) - Haig D (1993). "Genetic conflicts in human pregnancy". Q Rev Biol. 68 (4): 495–532. doi:10.1086/418300. PMID 8115596. الوسيط
|CitationClass=تم تجاهله (مساعدة) - Schuiling GA (2000). "Pre-eclampsia: a parent-offspring conflict". J Psychosom Obstet Gynaecol. 21 (3): 179–82. doi:10.3109/01674820009075626. PMID 11076340. مؤرشف من الأصل في 28 مارس 2020. الوسيط
|CitationClass=تم تجاهله (مساعدة) - Wedekind C, Seebeck T, Bettens F, Paepke AJ (1995). "MHC-dependent mate preferences in humans". Proc Biol Sci. 260 (1359): 245–9. doi:10.1098/rspb.1995.0087. PMID 7630893. الوسيط
|CitationClass=تم تجاهله (مساعدة)صيانة CS1: أسماء متعددة: قائمة المؤلفون (link) - Chaix R, Cao C, Donnelly P (2008). Przeworski, Molly (المحرر). "Is Mate Choice in Humans MHC-Dependent?". PLoS Genet. 4 (9): e1000184. doi:10.1371/journal.pgen.1000184. PMC 2519788. PMID 18787687. الوسيط
|CitationClass=تم تجاهله (مساعدة)صيانة CS1: أسماء متعددة: قائمة المؤلفون (link) - Crespi B, Badcock C (2008). "Psychosis and autism as diametrical disorders of the social brain". Behav Brain Sci. 31 (3): 241–61, discussion 261–320. doi:10.1017/S0140525X08004214. PMID 18578904. الوسيط
|CitationClass=تم تجاهله (مساعدة) - Nesse RM (2001). "The smoke detector principle. Natural selection and the regulation of defensive responses". Ann N Y Acad Sci. 935 (1): 75–85. doi:10.1111/j.1749-6632.2001.tb03472.x. PMID 11411177. مؤرشف من الأصل في 28 مارس 2020. الوسيط
|CitationClass=تم تجاهله (مساعدة) - Humphrey, Nicholas (2002). "19. Great Expectations: The Evolutionary Psychology of Faith-Healing and the Placebo Effect" (PDF). The mind made flesh: essays from the frontiers of psychology and evolution. Oxford [Oxfordshire]: Oxford University Press. صفحات 255–85. ISBN 0-19-280227-5. الوسيط
|CitationClass=تم تجاهله (مساعدة) - Eaton, S. Boyd; Konner, M; Shostak, M (April 1988). "Stone agers in the fast lane: chronic degenerative diseases in evolutionary perspective". American Journal of Medicine. 84 (4): 739–749. doi:10.1016/0002-9343(88)90113-1. PMID 3135745. مؤرشف من الأصل في 28 مارس 2020. اطلع عليه بتاريخ 18 يونيو 2010. الوسيط
|CitationClass=تم تجاهله (مساعدة) - William, Knowler (1978). "Diabetes incidence and prevalence in Pima Indians: a 19-fold greater incidence than in Rochester, Minnesota". American Journal of Epidemiology. 108 (6): 497–505. PMID 736028. مؤرشف من الأصل في 23 مارس 2007. اطلع عليه بتاريخ 18 يونيو 2010. الوسيط
|CitationClass=تم تجاهله (مساعدة) - Eaton SB, Strassman BI, Nesse RM, Neel JV, Ewald PW, Williams GC, Weder AB, Eaton SB 3rd, Lindeberg S, Konner MJ, Mysterud I, Cordain L (2002). "Evolutionary health promotion" (PDF). Prev Med. 34 (2): 109–18. doi:10.1006/pmed.2001.0876. PMID 11817903. مؤرشف من الأصل (PDF) في 16 فبراير 2010. الوسيط
|CitationClass=تم تجاهله (مساعدة)صيانة CS1: أسماء متعددة: قائمة المؤلفون (link) - Eaton SB (2006). "The ancestral human diet: what was it and should it be a paradigm for contemporary nutrition?". Proc Nutr Soc. 65 (1): 1–6. doi:10.1079/PNS2005471. PMID 16441938. الوسيط
|CitationClass=تم تجاهله (مساعدة) - Milton K (2003). "Micronutrient intakes of non-human primates: are humans different?" (PDF). Comparative Biochemistry and Physiology Part A. 136 (1): 47–59. doi:10.1016/S1095-6433(03)00084-9. PMID 14527629. مؤرشف من الأصل (PDF) في 5 يوليو 2019. الوسيط
|CitationClass=تم تجاهله (مساعدة) - Abuissa H, O’Keefe JH, Cordain, L (2005). "Realigning our 21st century diet and lifestyle with our hunter-gatherer genetic identity" (PDF). Directions Psych. 25: SR1–SR10. مؤرشف من الأصل (PDF) في 16 فبراير 2010. اطلع عليه بتاريخ أكتوبر 2020. الوسيط
|CitationClass=تم تجاهله (مساعدة); تحقق من التاريخ في:|تاريخ الوصول=(مساعدة)صيانة CS1: أسماء متعددة: قائمة المؤلفون (link) - Eaton, S. Boyd (2007). "The Ancestral Biomedical Environment" (PDF). In Aird, William C. (المحرر). Endothelial Biomedicine. Cambridge University Press. صفحات 129–34. ISBN 0-521-85376-1. الوسيط
|CitationClass=تم تجاهله (مساعدة) - Eaton SB, Eaton SB (2003 Sep). "An evolutionary perspective on human physical activity: implications for health". Comp Biochem Physiol a Mol Integr Physiol. 136 (1): 153–9. doi:10.1016/S1095-6433(03)00208-3. PMID 14527637. الوسيط
|CitationClass=تم تجاهله (مساعدة); تحقق من التاريخ في:|سنة=(مساعدة) - Cordain, L., Gotshall, R.W. and Eaton, S.B. (1998 Jul). "Physical activity, energy expenditure and fitness: an evolutionary perspective" (PDF). Int J Sports Med. 19 (5): 328–35. doi:10.1055/s-2007-971926. PMID 9721056. مؤرشف من الأصل (PDF) في 6 فبراير 2010. اطلع عليه بتاريخ أكتوبر 2020. الوسيط
|CitationClass=تم تجاهله (مساعدة); تحقق من التاريخ في:|تاريخ الوصول=, |سنة=(مساعدة)صيانة CS1: أسماء متعددة: قائمة المؤلفون (link) - Cordain, L., Gotshall, R.W., Eaton, S.B. (1997). "Evolutionary aspects of exercise" (PDF). World Rev Nutr Diet. 81: 49–60. doi:10.1159/000059601. ISBN 3-8055-6452-X. PMID 9287503. مؤرشف من الأصل (PDF) في 15 فبراير 2010. اطلع عليه بتاريخ أكتوبر 2020. الوسيط
|CitationClass=تم تجاهله (مساعدة); تحقق من التاريخ في:|تاريخ الوصول=(مساعدة)صيانة CS1: أسماء متعددة: قائمة المؤلفون (link) - PMID 20498671 (ببمد 20498671)
Citation will be completed automatically in a few minutes. Jump the queue or expand by hand - Kuzawa CW (1998). "Adipose tissue in human infancy and childhood: an evolutionary perspective". Am. J. Phys. Anthropol. 27: 177–209. PMID 9881526. الوسيط
|CitationClass=تم تجاهله (مساعدة) - Straub RH, Besedovsky HO (2003). "Integrated evolutionary, immunological, and neuroendocrine framework for the pathogenesis of chronic disabling inflammatory diseases". FASEB J. 17 (15): 2176–83. doi:10.1096/fj.03-0433hyp. PMID 14656978. الوسيط
|CitationClass=تم تجاهله (مساعدة) - Straub, R. H., del Rey, A., Besedovsky, H. O. (2007) "Emerging concepts for the pathogenesis of chronic disabling inflammatory diseases: neuroendocrine-immune interactions and evolutionary biology" In: Ader, R. (2007) "Psychoneuroimmunology", Volume 1, Academic Press, San Diego, pp.217-232
- Straub RH, Besedovsky HO, Del Rey A (2007). "[Why are there analogous disease mechanisms in chronic inflammatory diseases?]". Wien. Klin. Wochenschr. (باللغة الألمانية). 119 (15–16): 444–54. doi:10.1007/s00508-007-0834-z. PMID 17721763. الوسيط
|CitationClass=تم تجاهله (مساعدة)صيانة CS1: أسماء متعددة: قائمة المؤلفون (link) - Wick G, Berger P, Jansen-Dürr P, Grubeck-Loebenstein B (2003). "A Darwinian-evolutionary concept of age-related diseases". Exp. Gerontol. 38 (1–2): 13–25. doi:10.1016/S0531-5565(02)00161-4. PMID 12543257. مؤرشف من الأصل في 19 يونيو 2018. الوسيط
|CitationClass=تم تجاهله (مساعدة)صيانة CS1: أسماء متعددة: قائمة المؤلفون (link) - Bogin , B. (1997) "Evolutionary hypotheses for human childhood". Yearbook of Physical Anthropology. 104: 63-89 abstract [وصلة مكسورة] نسخة محفوظة 28 مارس 2020 على موقع واي باك مشين.
- Gluckman PD, Hanson MA (2006). "Evolution, development and timing of puberty". Trends Endocrinol. Metab. 17 (1): 7–12. doi:10.1016/j.tem.2005.11.006. PMID 16311040. الوسيط
|CitationClass=تم تجاهله (مساعدة) - Kuhle BX (2007). "An evolutionary perspective on the origin and ontogeny of menopause". Maturitas. 57 (4): 329–37. doi:10.1016/j.maturitas.2007.04.004. PMID 17544235. الوسيط
|CitationClass=تم تجاهله (مساعدة) - Profet M (1993). "Menstruation as a defense against pathogens transported by sperm". Q Rev Biol. 68 (3): 335–86. doi:10.1086/418170. PMID 8210311. الوسيط
|CitationClass=تم تجاهله (مساعدة) - Strassmann BI (1996). "The evolution of endometrial cycles and menstruation". Q Rev Biol. 71 (2): 181–220. doi:10.1086/419369. PMID 8693059. الوسيط
|CitationClass=تم تجاهله (مساعدة) - Finn, C. A. (1998). "Menstruation: A nonadaptive consequence of uterine evolution". The Quarterly review of biology. 73 (2): 163–173. PMID 9618925. الوسيط
|CitationClass=تم تجاهله (مساعدة) - Flaxman SM, Sherman PW (2000). "Morning sickness: a mechanism for protecting mother and embryo". Q Rev Biol. 75 (2): 113–48. doi:10.1086/393377. PMID 10858967. الوسيط
|CitationClass=تم تجاهله (مساعدة) - Flaxman SM, Sherman PW (2008). "Morning sickness: adaptive cause or nonadaptive consequence of embryo viability?". Am. Nat. 172 (1): 54–62. doi:10.1086/588081. PMID 18500939. الوسيط
|CitationClass=تم تجاهله (مساعدة) - Wick G, Perschinka H, Millonig G (2001). "Atherosclerosis as an autoimmune disease: an update". Trends Immunol. 22 (12): 665–9. doi:10.1016/S1471-4906(01)02089-0. PMID 11738996. مؤرشف من الأصل في 19 يونيو 2018. الوسيط
|CitationClass=تم تجاهله (مساعدة)صيانة CS1: أسماء متعددة: قائمة المؤلفون (link) - Rotter JI, Diamond JM (1987). "What maintains the frequencies of human genetic diseases?". Nature. 329 (6137): 289–90. doi:10.1038/329289a0. PMID 3114647. الوسيط
|CitationClass=تم تجاهله (مساعدة) - PMID 14666533 (ببمد 14666533)
Citation will be completed automatically in a few minutes. Jump the queue or expand by hand - NEEL JV (1962). "Diabetes Mellitus: A "Thrifty" Genotype Rendered Detrimental by "Progress"?". Am. J. Hum. Genet. 14 (4): 353–62. PMC 1932342. PMID 13937884. الوسيط
|CitationClass=تم تجاهله (مساعدة) - Neel JV, Weder AB, Julius S (1998). "Type II diabetes, essential hypertension, and obesity as "syndromes of impaired genetic homeostasis": the "thrifty genotype" hypothesis enters the 21st century". Perspect. Biol. Med. 42 (1): 44–74. PMID 9894356. الوسيط
|CitationClass=تم تجاهله (مساعدة)صيانة CS1: أسماء متعددة: قائمة المؤلفون (link) - Williams, George; Nesse, Randolph M. (1996). "Evolution and healing". Why we get sick: the new science of Darwinian medicine. New York: Vintage Books. صفحات 37–8. ISBN 0-679-74674-9. الوسيط
|CitationClass=تم تجاهله (مساعدة)صيانة CS1: أسماء متعددة: قائمة المؤلفون (link) - Wick G, Jansen-Dürr P, Berger P, Blasko I, Grubeck-Loebenstein B (2000). "Diseases of aging". Vaccine. 18 (16): 1567–83. doi:10.1016/S0264-410X(99)00489-2. PMID 10689131. مؤرشف من الأصل في 19 يونيو 2018. الوسيط
|CitationClass=تم تجاهله (مساعدة)صيانة CS1: أسماء متعددة: قائمة المؤلفون (link) - Kluger MJ, Ringler DH, Anver MR (1975). "Fever and survival". Science. 188 (4184): 166–8. doi:10.1126/science.1114347. PMID 1114347. مؤرشف من الأصل في 28 مارس 2020. الوسيط
|CitationClass=تم تجاهله (مساعدة)صيانة CS1: أسماء متعددة: قائمة المؤلفون (link) - Kluger MJ, Rothenburg BA (1979). "Fever and reduced iron: their interaction as a host defense response to bacterial infection". Science. 203 (4378): 374–6. doi:10.1126/science.760197. PMID 760197. مؤرشف من الأصل في 28 مارس 2020. الوسيط
|CitationClass=تم تجاهله (مساعدة) - Ames BN, Cathcart R, Schwiers E, Hochstein P (1981). "Uric acid provides an antioxidant defense in humans against oxidant- and radical-caused aging and cancer: a hypothesis". Proc. Natl. Acad. Sci. U.S.A. 78 (11): 6858–62. doi:10.1073/pnas.78.11.6858. PMC 349151. PMID 6947260. الوسيط
|CitationClass=تم تجاهله (مساعدة)صيانة CS1: أسماء متعددة: قائمة المؤلفون (link) - Naugler C (2008). "Hemochromatosis: a Neolithic adaptation to cereal grain diets". Med. Hypotheses. 70 (3): 691–2. doi:10.1016/j.mehy.2007.06.020. PMID 17689879. الوسيط
|CitationClass=تم تجاهله (مساعدة) - Moalem S, Percy ME, Kruck TP, Gelbart RR (2002). "Epidemic pathogenic selection: an explanation for hereditary hemochromatosis?". Med. Hypotheses. 59 (3): 325–9. doi:10.1016/S0306-9877(02)00179-2. PMID 12208162. مؤرشف من الأصل في 21 يونيو 2018. الوسيط
|CitationClass=تم تجاهله (مساعدة)صيانة CS1: أسماء متعددة: قائمة المؤلفون (link) - Wander K, Shell-Duncan B, McDade TW (2008). "Evaluation of iron deficiency as a nutritional adaptation to infectious disease: An evolutionary medicine perspective". Am. J. Hum. Biol. 21 (2): 172–9. doi:10.1002/ajhb.20839. PMID 18949769. الوسيط
|CitationClass=تم تجاهله (مساعدة)صيانة CS1: أسماء متعددة: قائمة المؤلفون (link) - Eaton SB, Eaton SB, Konner MJ (1997). "Paleolithic nutrition revisited: a twelve-year retrospective on its nature and implications". Eur J Clin Nutr. 51 (4): 207–16. doi:10.1038/sj.ejcn.1600389. PMID 9104571. الوسيط
|CitationClass=تم تجاهله (مساعدة)صيانة CS1: أسماء متعددة: قائمة المؤلفون (link) - Eaton SB, Konner M (1985). "Paleolithic nutrition. A consideration of its nature and current implications". N. Engl. J. Med. 312 (5): 283–9. doi:10.1056/NEJM198501313120505. PMID 2981409. الوسيط
|CitationClass=تم تجاهله (مساعدة) - Woolf LI, McBean MS, Woolf FM, Cahalane SF (1975). "Phenylketonuria as a balanced polymorphism: the nature of the heterozygote advantage". Ann. Hum. Genet. 38 (4): 461–9. doi:10.1111/j.1469-1809.1975.tb00635.x. PMID 1190737. الوسيط
|CitationClass=تم تجاهله (مساعدة)صيانة CS1: أسماء متعددة: قائمة المؤلفون (link) - Karasik, D. (Nov 2008). "Osteoporosis: an evolutionary perspective". Human Genetics. 124 (4): 349–356. doi:10.1007/s00439-008-0559-8. ISSN 0340-6717. PMID 18781328. الوسيط
|CitationClass=تم تجاهله (مساعدة) - Williams TN (2006). "Human red blood cell polymorphisms and malaria". Curr. Opin. Microbiol. 9 (4): 388–94. doi:10.1016/j.mib.2006.06.009. PMID 16815736. الوسيط
|CitationClass=تم تجاهله (مساعدة) - Ayi K, Turrini F, Piga A, Arese P (2004). "Enhanced phagocytosis of ring-parasitized mutant erythrocytes: a common mechanism that may explain protection against falciparum malaria in sickle trait and beta-thalassemia trait". Blood. 104 (10): 3364–71. doi:10.1182/blood-2003-11-3820. PMID 15280204. الوسيط
|CitationClass=تم تجاهله (مساعدة)صيانة CS1: أسماء متعددة: قائمة المؤلفون (link) - Williams TN; Mwangi TW; Wambua S; et al. (2005). "Sickle cell trait and the risk of Plasmodium falciparum malaria and other childhood diseases". J. Infect. Dis. 192 (1): 178–86. doi:10.1086/430744. PMID 15942909. الوسيط
|CitationClass=تم تجاهله (مساعدة)CS1 maint: extra punctuation (link) - Hart BL (1988). "Biological basis of the behavior of sick animals". Neurosci Biobehav Rev. 12 (2): 123–37. doi:10.1016/S0149-7634(88)80004-6. PMID 3050629. مؤرشف من الأصل في 12 يونيو 2018. الوسيط
|CitationClass=تم تجاهله (مساعدة) - Eaton SB; Pike MC; Short RV; et al. (1994). "Women's reproductive cancers in evolutionary context". Q Rev Biol. 69 (3): 353–67. doi:10.1086/418650. PMID 7972680. الوسيط
|CitationClass=تم تجاهله (مساعدة)CS1 maint: extra punctuation (link) - Nesse, R., & Williams, G. (1996) Why we get sick. NY: Vintage.
- Gaulin, Steven J. C. and Donald H. McBurney. Evolutionary psychology. Prentice Hall. 2003. (ردمك 978-0-13-111529-3), Chapter 1, p 1-24.
- Buss, D.M. (2011). Evolutionary Psychology.
- Gaulin & McBurney (2004), Evolutionary Psychology
- Workman & Reader (2004), Evolutionary Psychology
- Nesse R (1997). "An evolutionary perspective on panic disorder and agoraphobia". In Baron-Cohen S (المحرر). The maladapted mind: classic readings in evolutionary psychopathology. East Sussex: Psychology Press. صفحات 73–84. ISBN 0-86377-460-1. مؤرشف من الأصل في 28 مارس 2020. اطلع عليه بتاريخ 21 يناير 2011. الوسيط
|CitationClass=تم تجاهله (مساعدة) - Grinde B (2005). "An approach to the prevention of anxiety-related disorders based on evolutionary medicine". Prev Med. 40 (6): 904–9. doi:10.1016/j.ypmed.2004.08.001. PMID 15850894. الوسيط
|CitationClass=تم تجاهله (مساعدة) - Nesse RM (2000). "Is depression an adaptation?". Arch. Gen. Psychiatry. 57 (1): 14–20. doi:10.1001/archpsyc.57.1.14. PMID 10632228. مؤرشف من الأصل في 28 مارس 2020. الوسيط
|CitationClass=تم تجاهله (مساعدة) - Nesse RM, Berridge KC (1997). "Psychoactive drug use in evolutionary perspective". Science. 278 (5335): 63–6. doi:10.1126/science.278.5335.63. PMID 9311928. مؤرشف من الأصل في 28 مارس 2020. الوسيط
|CitationClass=تم تجاهله (مساعدة) - Crow TJ (1995). "A Darwinian approach to the origins of psychosis". Br J Psychiatry. 167 (1): 12–25. doi:10.1192/bjp.167.1.12. PMID 7551604. الوسيط
|CitationClass=تم تجاهله (مساعدة) - Brüne M (2004). "Schizophrenia-an evolutionary enigma?". Neurosci Biobehav Rev. 28 (1): 41–53. doi:10.1016/j.neubiorev.2003.10.002. PMID 15036932. الوسيط
|CitationClass=تم تجاهله (مساعدة) - Nesse RM (2004). "Natural selection and the elusiveness of happiness". Philos. Trans. R. Soc. Lond., B, Biol. Sci. 359 (1449): 1333–47. doi:10.1098/rstb.2004.1511. PMC 1693419. PMID 15347525. الوسيط
|CitationClass=تم تجاهله (مساعدة)
كتابات أخرى
كتب
- Williams, George; Nesse, Randolph M. (1996). Why we get sick: the new science of Darwinian medicine. New York: Vintage Books. ISBN 0-679-74674-9. الوسيط
|CitationClass=تم تجاهله (مساعدة)صيانة CS1: أسماء متعددة: قائمة المؤلفون (link) - Stearns SC, Koella JK (2008). Evolution in health and disease (الطبعة 2nd). Oxford [Oxfordshire]: Oxford University Press. ISBN 0-19-920745-3. الوسيط
|CitationClass=تم تجاهله (مساعدة) - McKenna, James J.; Trevathan, Wenda; Smith, Euclid O. (2008). Evolutionary medicine and health: new perspectives (الطبعة 2nd). Oxford [Oxfordshire]: Oxford University Press. ISBN 0-19-530706-2. الوسيط
|CitationClass=تم تجاهله (مساعدة)صيانة CS1: أسماء متعددة: قائمة المؤلفون (link) - O'Higgins, Paul; Sarah Elton (2008). Medicine and Evolution: Current Applications, Future Prospects (Society for the Study of Human Biology Symposium Series (Sshb)). Boca Raton: CRC. ISBN 1-4200-5134-2. الوسيط
|CitationClass=تم تجاهله (مساعدة)صيانة CS1: أسماء متعددة: قائمة المؤلفون (link) - Ewald, P. W. (1996). Evolution of Infectious Disease. Oxford: Oxford University Press. ISBN 0-19-511139-7. الوسيط
|CitationClass=تم تجاهله (مساعدة) - Moalem, S. (2007). Survival of the Sickest. New York: HarperLuxe. ISBN 978-0-06-088965-4. الوسيط
|CitationClass=تم تجاهله (مساعدة)
مقالات عبر الإنترنت
- Straub, RH. (2003). "Integrated evolutionary, immunological, and neuroendocrine framework for the pathogenesis of chronic disabling inflammatory diseases". FASEB J. 17 (15): 2176–2183. doi:10.1096/fj.03-0433hyp. PMID 14656978. مؤرشف من الأصل في 04 يوليو 2008. الوسيط
|CitationClass=تم تجاهله (مساعدة) - LeGrand, E. K. (1 July 2002). "Darwinian medicine: Applications of evolutionary biology for veterinarians". Canadian Veterinary Journal. 43 (7): 556–9. ISSN 0008-5286. PMC 341948. PMID 12125190. الوسيط
|CitationClass=تم تجاهله (مساعدة) - Randolph M. Nesse, Stephen C. Stearns (2008). "The great opportunity: Evolutionary applications to medicine and public health" (PDF). Evolutionary Applications. 1 (1): 28–48. doi:10.1111/j.1752-4571.2007.00006.x. مؤرشف من الأصل (PDF) في 28 مارس 2020. الوسيط
|CitationClass=تم تجاهله (مساعدة) - Naugler, Christopher T. (1 September 2008). "Evolutionary medicine: Update on the relevance to family practice". Canadian Family Physician. 54 (9): 1265–9. PMC 2553465. PMID 18791103. مؤرشف من الأصل في 24 أبريل 2010. الوسيط
|CitationClass=تم تجاهله (مساعدة) - Childs, B. (2005). "A science of the individual: Implications for a medical school curriculum". Annual Review of Genomics and Human Genetics. 6 (1): 313–330. doi:10.1146/annurev.genom.6.080604.162345. PMID 16124864. الوسيط
|CitationClass=تم تجاهله (مساعدة) - Stiehm ER (2006). "Disease versus disease: how one disease may ameliorate another". Pediatrics. 117 (1): 184–91. doi:10.1542/peds.2004-2773. PMID 16396876. مؤرشف من الأصل في 02 نوفمبر 2009. الوسيط
|CitationClass=تم تجاهله (مساعدة)
وصلات خارجية
- The Evolution and Medicine Review
- Evolution and Medicine Network
- الموقع الإلكتروني لراندولف إم. نيسي
- Steve Lewis's new Evolutionary Medicine site
- Special Issue of Evolutionary Applications on Evolutionary Medicine
- Publications in evolutionary medicine and further aspects of human evolution
- بوابة طب
- بوابة علم الأحياء التطوري
- بوابة علم النفس